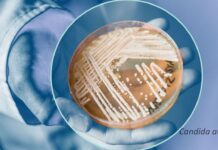
Funghi e Malattie

Tag: economia
Il granaio d’Europa
Da "Granaio d'Europa" a "Grana d'Europa" - Nonostante l’impegno economico e militare dell’occidente, l’Ucraina sta arrancando e la vittoria (non si può usare la...
Sotto l’ombra della peste suina: il destino della filiera del prosciutto...
Di Nicola Comparato Felino, 12 aprile 2024 -
"Nel cuore della regione emiliana, dove la tradizione culinaria si mescola con l'arte dell'affinamento, si trova Langhirano, nota...
VINITALY 2024: il Parmigiano Reggiano mette in mostra la sua versatilità...
Previste 16 degustazioni di varie stagionature e biodiversità della Dop in pairing con Chianti Classico, Franciacorta, Lambrusco, Pignoletto, Valpolicella, birre, le creazioni di Cantine...
Sabato 20 e Domenica 21 Aprile torna Caseifici Aperti, l’appuntamento primaverile...
Dopo il grande successo delle due edizioni 2023, che hanno registrato 24.500 partecipanti con un aumento del 19,5% sul 2022, i produttori del Parmigiano...
“Cereali e dintorni” – perché i mercati stanno congelando.
Difficilmente potranno riproporsi i dati del 2021.
Di Mario Boggini e Virgilio Milano, 11 aprile 2024
Molti lettori ed operatori, visti i valori delle farine...
Fiere di Parma, tra i poli fieristici più “in salute” d’Europa:nel...
Ricavi oltre 41 milioni di euro e una posizione finanziaria netta di oltre 14 milioni di euro, con un free cash di 25, fanno del polo di Parma, l’unico con...
Parmigiano Reggiano: l’Assemblea generale dei consorziati approva il bilancio consuntivo 2023.
Dibattito con i soci per l’impostazione del nuovo piano regolazione offerta 2026-2031
Il bilancio consuntivo 2023 si è chiuso con un utile di esercizio pari...
Due giorni alla Conferenza Internazionale del Vino
Proteggere e valorizzare il vino sui mercati europei ed internazionali sarà il tema prioritario della Conferenza Internazionale sul Vino (“Wine Ministerial Meeting”), organizzata insieme all’Organizzazione...
Cibus Agenzia Stampa Agroalimentare: SOMMARIO Anno 23 – n° 14 7...
Editoriale: -Perché uscire da META / FACEBOOK - Lattiero Caseario: “Cedono latte e burro” - “Cereali e dintorni” - Il mercato è mobile. -...
Perché uscire da META / FACEBOOK
Trasparenza e Censura. Troppi censori e spocchiosi giudici si ergono a difesa di non si sa quali interessi collettivi.
Di Lamberto Colla Parma, 7 aprile...